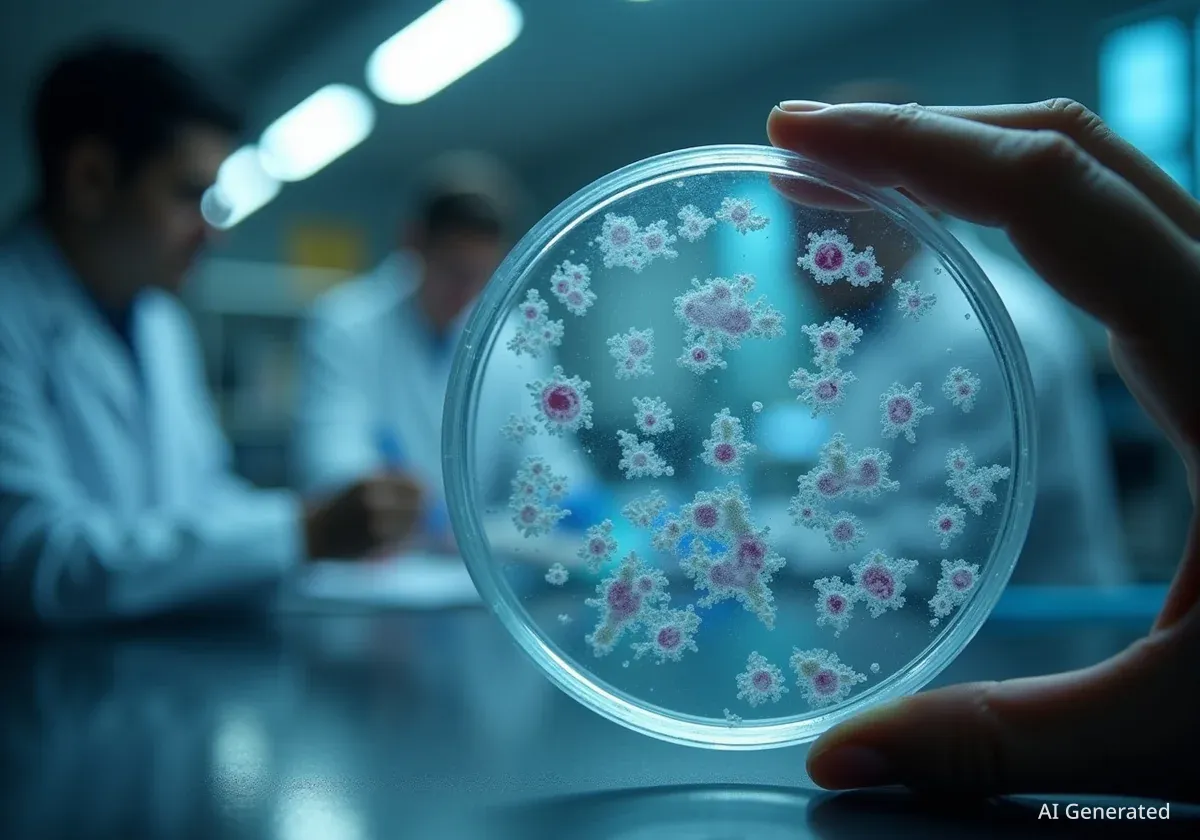
Crean un cóctel de virus para combatir superbacterias hospitalarias

Crean un cóctel de virus para combatir superbacterias hospitalarias
Científicos australianos crean un cóctel de cinco virus llamado Entelli-02 que combate eficazmente una superbacteria hospitalaria resistente a los antibióticos.
#Superbacterias#Resistencia a los antibióticos#Terapia con fagos


